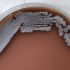
India COVID death toll crosses 400,000 – half died in second wave | Coronavirus pandemic News

India has reached the grim milestone of 400,000 deaths from the coronavirus, half of them during a second wave in the past few months that overwhelmed the healthcare system and crematoriums.
India has recorded 30.45 million cases since the outbreak of the pandemic last year and is the second-most affected country behind the United States, which has 33 million cases.
The US has at least 604,000 deaths and about 518,000 people have died in Brazil.
India, the world’s second-most populous nation, recorded 853 deaths in the past 24 hours, health ministry data showed on Friday. That took it past the 400,000 mark, with the last 100,000 being added in just 39 days, according to a Reuters news agency tally.
But health experts believe India may have undercounted deaths significantly and the actual number could have reached one million or even higher.
Scores of bodies washed up along the Ganges river in northern India in May, as people struggled to keep pace with deaths and cremations at the peak of the second wave.
“Undercounting of deaths is something that has happened across states, mostly because of lags in the system, so that means we will never have a true idea of how many people we lost in this second wave,” said Rijo M John, a professor at the Rajagiri College of Social Sciences in the southern city of Kochi.
Last month, Bihar, one of India’s poorest states, revised its total COVID-19 death toll to 9,429 from 5,424 after an order from a local court.
India recorded a total of 200,000 deaths at the end of April, but took just 28 days to get to 300,000 deaths.
Hospitals ran out of beds and life-saving oxygen during the second wave in April and May and people died in parking lots outside hospitals and at their homes.
Cases have declined steadily since hitting a peak in May, but government officials and experts have warned that a third wave looms, as the country slowly reopens and a new variant, locally called the Delta Plus, rears its head.
 Shivaji Veer, 51, a school bus driver waits to board a taxi to go home after a follow-up consultation at a hospital after losing his eye due to mucormycosis [Francis Mascarenhas/Reuters]
Shivaji Veer, 51, a school bus driver waits to board a taxi to go home after a follow-up consultation at a hospital after losing his eye due to mucormycosis [Francis Mascarenhas/Reuters]‘Black fungus’ robs some of eyesight
Saheb Rao Shinde’s family thought the worst was over when the 65-year-old recovered from COVID-19 last month at his home in western India. But a few weeks later, the revenue-stamp vendor lost sight in one eye.
During the catastrophic second wave of COVID-19, thousands who contracted the virus also suffered from a rare fungal disease called mucormycosis, or “black fungus”.
India has so far reported more than 40,845 cases of mucormycosis.
 Patients suffering from ‘black fungus’ seen inside a hospital ward in Ahmedabad [Amit Dave/Reuters]
Patients suffering from ‘black fungus’ seen inside a hospital ward in Ahmedabad [Amit Dave/Reuters]
Many like Shinde may never be able to regain their sight after the fungal disease which causes blackening or discolouration over the nose, blurred or double vision, chest pain, breathing difficulties and coughing blood.
“Father was fit and healthy, now he doesn’t feel like eating …” said his daughter, who did not want to be named. “His teeth have also been removed, it’s very sad.”
Shinde, from the arid western Indian region of Marathwada in Maharashtra state, will resume work after he recovers from this, his daughter told Reuters in Mumbai.
Adesh Kumar, a 39-year-old farmer in the northern state of Uttar Pradesh, lost sight in his left eye. He had to borrow money to pay for medicine, secured against some of his land.
India ordered tighter surveillance of mucormycosis in May as it compounded the challenge for COVID-19 patients, especially those on steroid therapy and with diabetes.
Experts say an overuse of certain drugs which suppress the immune system could be causing the surge of the fungal infection.
“We are seeing a lot of mucormycosis cases post COVID infections, since COVID itself is known to decrease the immunity,” said Charuta Mandke of the ophthalmology department at Dr R N Cooper Municipal General Hospital in Mumbai.